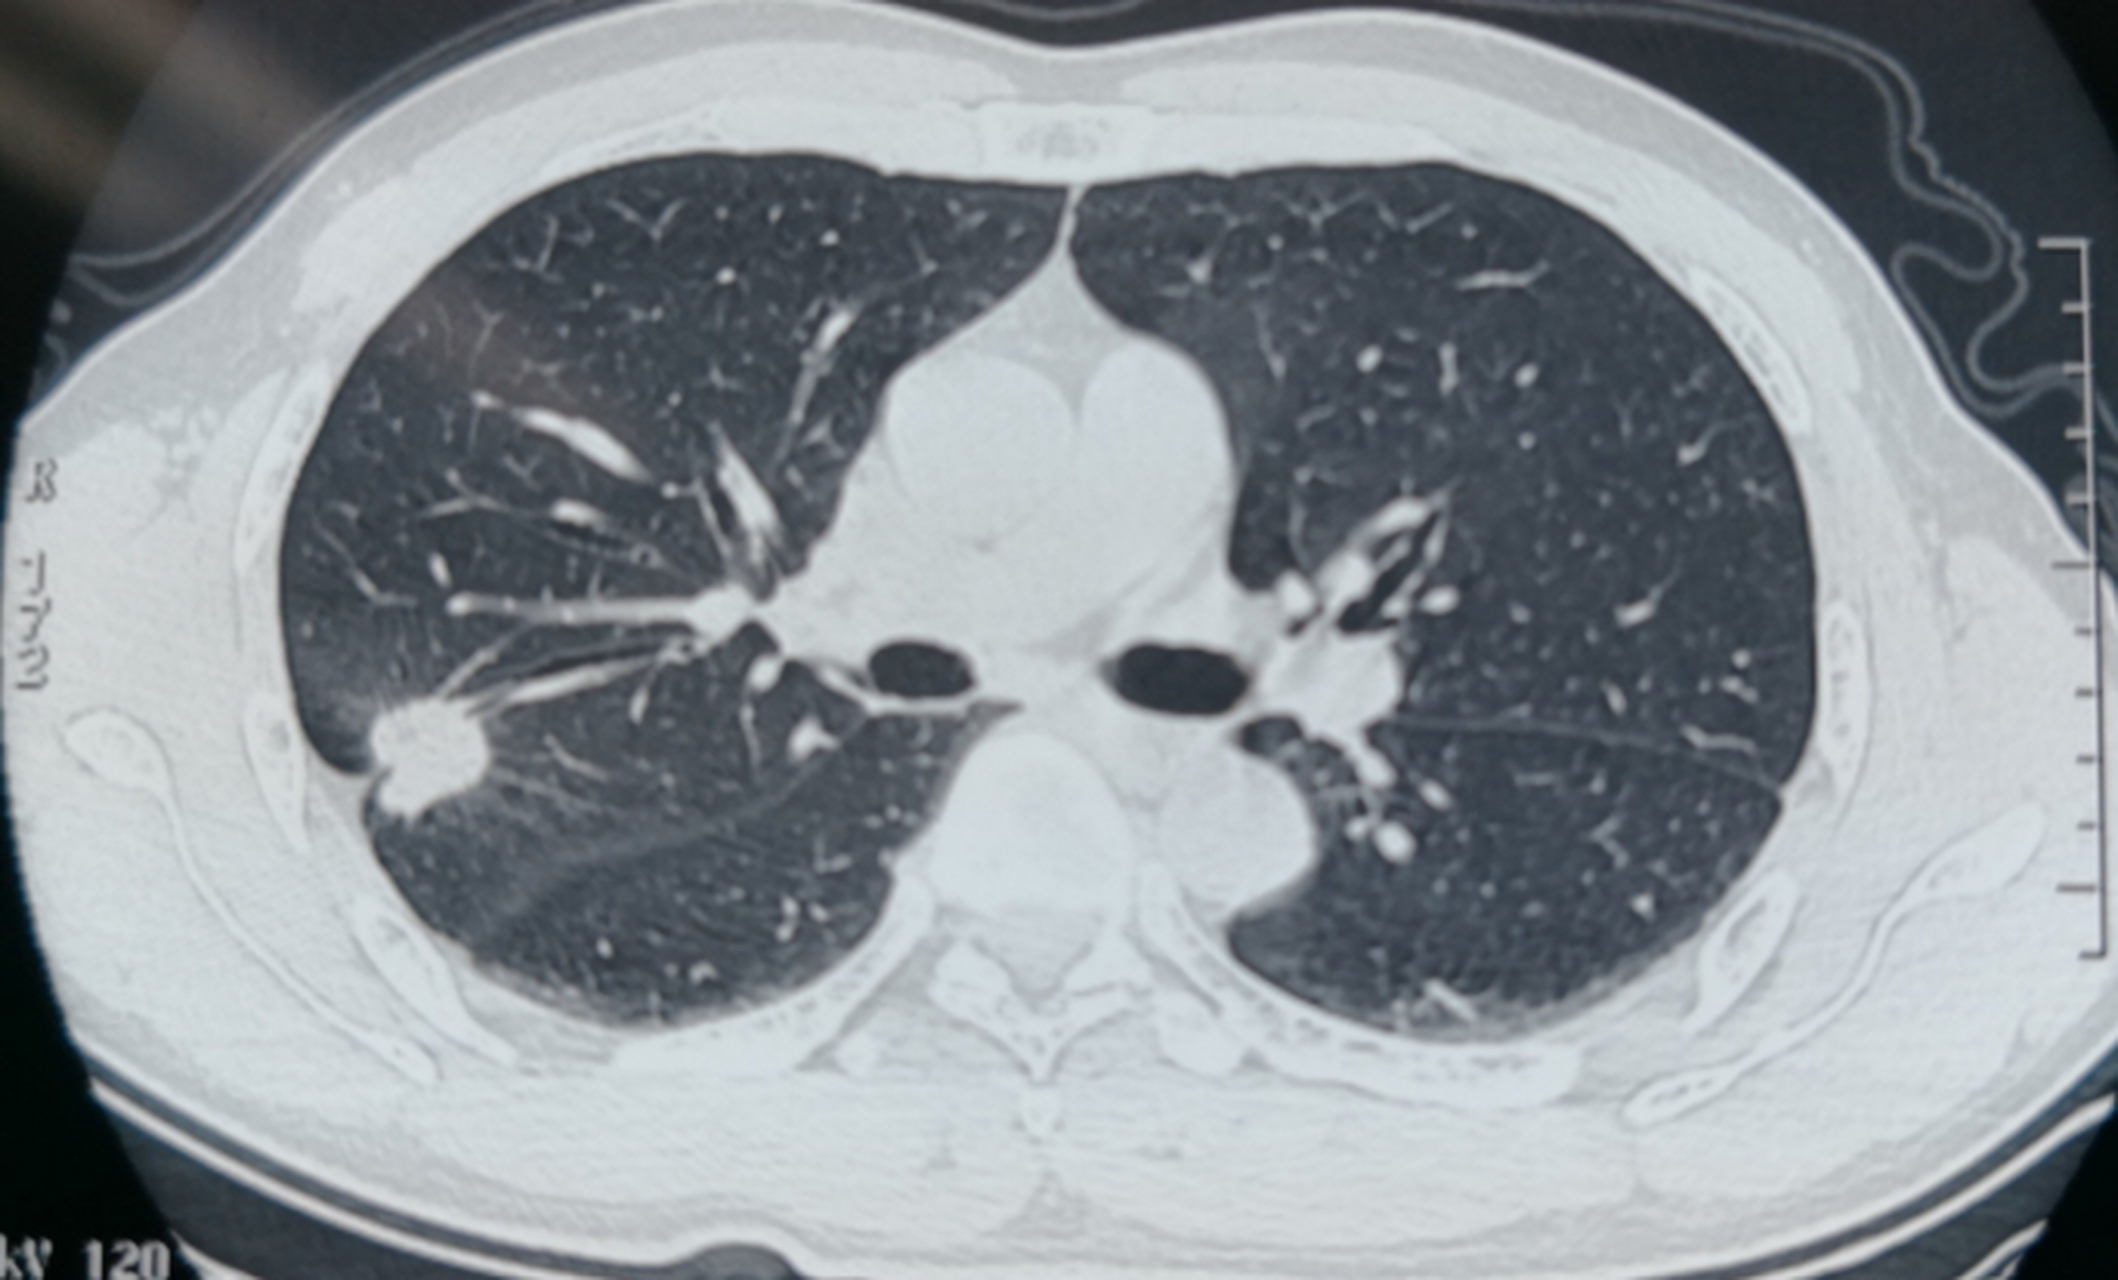
太揪心了,父亲确诊了肺癌晚期,脊柱转移,每天疼得唉唉叫.

肺癌x光

典型的肺癌
图片尺寸2709x2651
胸部x光片显示右肺有肿瘤
图片尺寸1054x1200
肺癌发生悄无声息,一旦四肢有4种"标记",当心肺癌已在路上!
图片尺寸639x522
早期肺癌可以治愈正确治疗存活率可达88
图片尺寸640x344
(图) 大细胞中分化型肺癌
图片尺寸947x1095
晚期肺癌到底有多痛苦告诉你关于肺癌的5个真相
图片尺寸640x717
起床3个"警报"一出,烟瘾再大也得戒,否则肺癌可能会步步紧逼
图片尺寸640x720
刘懿博士说肺癌一二二三脸肿去了心脏科消化科今天到了肺外科
图片尺寸2562x3162
肺癌的线表现
图片尺寸1417x886
影像学经典片库1
图片尺寸1080x810
刘懿博士说肺癌三七〇四胸片发现问题没重视肺癌耽误了八个月
图片尺寸1600x1435
平时不抽烟也不喝酒,为什么这位鲍女士还是得了肺癌?
图片尺寸640x663
西安市第九医院为一例肺癌化疗患者实施picc置管手术
图片尺寸600x597
肺癌分期是怎么定的有什么区别吗
图片尺寸1016x867
医学影像学第七版 肺肿瘤ppt
图片尺寸1080x810
图2204小细胞低分化型肺癌
图片尺寸987x1063
肺癌晚期吃什么药管用 就是肺管上长的瘤 急急急 谢谢
图片尺寸499x281
太揪心了,父亲确诊了肺癌晚期,脊柱转移,每天疼得唉唉叫.
图片尺寸2118x1280
基础学习中央型肺癌典型征象
图片尺寸1080x608
女性吸烟者的数码胸部x光片显示肺癌
图片尺寸1067x1200